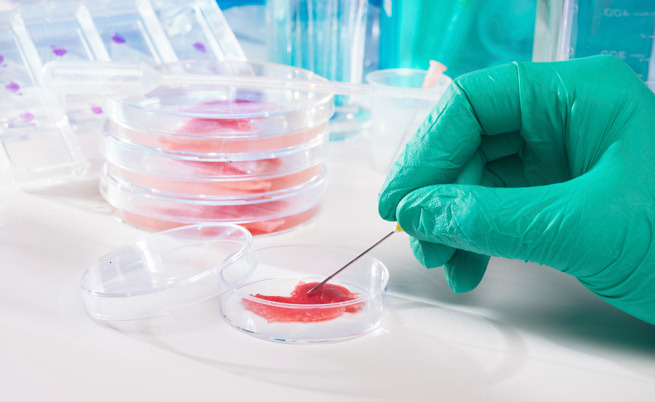

Che la carne rossa non sia un toccasana per la nostra salute è oramai cosa nota. La cancerogenità della carne è la causa dell'insorgere di gravi tumori che possono peggiorare irreversibilmente le condizioni di vita dei pazienti colpiti.
Ma quali sono con esattezza le cause che provocano queste patologie?
Come sottolineato dal professor zur Hausen, durante la serata di premiazione per il ‘Science of Oncology’, al congresso dell’ASCO a Chicago, "i tumori legati a un'alimentazione ricca di carne sono anche correlabili a qualche forma di malattia infettiva".
Le parassitosi, come la Schistosomiasi, il Clonorchis, l'Opisthorchis, le malattie batteriche, come l'Helicobacter pylori, e le infezioni virali, sono molto comuni per chi mangia carne cruda, e possono essere gli agenti scatenati di diversi tipi di cancro.
Dopo una serie di indagini, è emerso che uno dei rischi più grandi per gli amanti degli hamburger al sangue riguarda la possibilità di essere colpiti da tumore al colon. In particolare, il consumo di manzo potrebbe aumentarne i rischi del 20-30%, valutando anche i dati che emergono dai paesi con un maggior consumo.
La cancerogenità della carne
Una spiegazione patogenetica è certamente legata al fatto che, durante la cottura, le carni rosse generano dei cancerogeni chimici che, nella fase di digestione e defecazione, attraversano il colon.
In realtà, questa è solo una delle cause, come già detto. Il prof zur Hausen afferma, infatti, che il tumore del colon retto nell’uomo potrebbe essere causato anche da un virus, termo-resistente e presente nella carne poco cotta, che agirebbe nell'intestino.
L'insieme di tutti i fattori porterebbe quindi a una forma di malattia oncologica grave.
Lo studio
Per validare le tesi sempre più forti sull'argomento, alcuni ricercatori tedeschi hanno analizzato i sieri di 130 manzi europei in buona salute, sequenziando il DNA. Hanno poi isolato un ampio numero di DNA a singolo filamento circolare, trovando un legame con le famiglie degli Anellovirus e dei Circovirus.
Queste stesse sequenze di DNA circolare a singolo filamento non sono state però ritrovate all’interno delle linee cellulari del tumore del colon, ma pare possano essere legate a un'altra patologia neurologica cronica, non tumorale.
Sembra comunque che altri due tumori possano essere invece causati dalla carne: quello al seno e ai polmoni.
Uno studio, pubblicato sul British Medical Journal, evidenzierebbe che in 20 anni circa 2.830 casi di tumore sono comparsi in soggetti che consumavano più carni rosse.
Insomma, i dubbi e le indagini restano ancora aperte, ma la certezza che eccedere nel consumo di carne rossa possa comportare un grave rischio per la salute è oramai di dominio pubblico.
Bisognerebbe aprire la propria cultura anche a diete ancora non "nazional-popolari", come quella vegetariana e quella vegana, scoprendo il piacere di ritrovare nei sapori semplici e nelle tradizioni tutta la bontà di cibi sani e naturali.